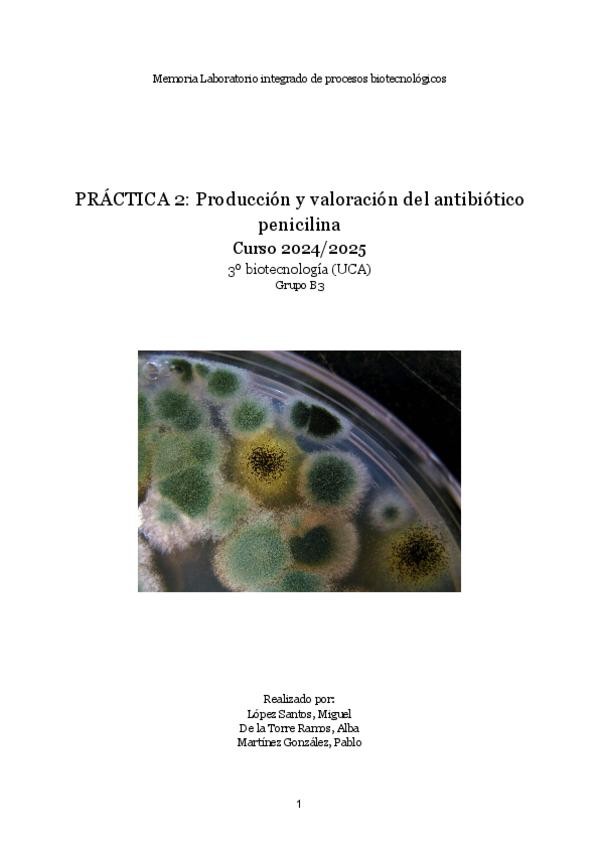

Laboratorio Integrado de Procesos Biotecnológicos
He publicado nuevos test de 3º Laboratorio Integrado de Procesos Biotecnológicos: Tests-diarios.pdf
practicas
-
practicas LIPROC
He publicado nuevos practicas de 3º Laboratorio Integrado de Procesos Biotecnológicos: practicas LIPROC
He publicado nuevos examenes de 3º Laboratorio Integrado de Procesos Biotecnológicos: EXAM-semana-3-LIPROC.pdf
apuntes
-
Guiones + algunas explicaciones
He publicado nuevos apuntes de 3º Laboratorio Integrado de Procesos Biotecnológicos: Guiones + algunas explicaciones
He publicado nuevos examenes de 3º Laboratorio Integrado de Procesos Biotecnológicos: Recopilacion-de-EXAMENES-LIPROC.pdf
He publicado nuevos examenes de 3º Laboratorio Integrado de Procesos Biotecnológicos: Convocatoria-Junio-2025-LIPROC.pdf
He publicado nuevos examenes de 3º Laboratorio Integrado de Procesos Biotecnológicos: Convocatoria-Junio-2024-LIPROC.pdf
He publicado nuevos examenes de 3º Laboratorio Integrado de Procesos Biotecnológicos: Convocatoria-Junio-2021-LIPROC.pdf
He publicado nuevos practicas de 3º Laboratorio Integrado de Procesos Biotecnológicos: Practica-1-LIPROC.pdf
He publicado nuevos practicas de 3º Laboratorio Integrado de Procesos Biotecnológicos: Practica-2-LIPROC.pdf
He publicado nuevos practicas de 3º Laboratorio Integrado de Procesos Biotecnológicos: Practica-3-LIPROC.pdf
He publicado nuevos practicas de 3º Laboratorio Integrado de Procesos Biotecnológicos: Practica-4-catalasa-LIPROC.pdf
He publicado nuevos practicas de 3º Laboratorio Integrado de Procesos Biotecnológicos: Practica-2.-Penicilina-LIPROC.pdf
He publicado nuevos test de 3º Laboratorio Integrado de Procesos Biotecnológicos: test-liproc-3-semana.pdf
He publicado nuevos apuntes de 3º Laboratorio Integrado de Procesos Biotecnológicos: TEST-LIPROC-SEMANA-2.pdf
He publicado nuevos test de 3º Laboratorio Integrado de Procesos Biotecnológicos: TEST-LIPROC-SEMANA-1.pdf
He publicado nuevos examenes de 3º Laboratorio Integrado de Procesos Biotecnológicos: LIprocjunio24Examen.pdf
He publicado nuevos apuntes de 3º Laboratorio Integrado de Procesos Biotecnológicos: informe-fermentacion.pdf
He publicado nuevos practicas de 3º Laboratorio Integrado de Procesos Biotecnológicos: PRACTICA-4.pdf
He publicado nuevos practicas de 3º Laboratorio Integrado de Procesos Biotecnológicos: PRACTICA-2.pdf
He publicado nuevos practicas de 3º Laboratorio Integrado de Procesos Biotecnológicos: LIPROC.-memoria.pdf
He publicado nuevos apuntes de 3º Laboratorio Integrado de Procesos Biotecnológicos: RESUMEN-IMPORTANTE--PROBLEMAS-FINALES.pdf
He publicado nuevos test de 3º Laboratorio Integrado de Procesos Biotecnológicos: Recopilatorio-preguntas-test-LIPROC.pdf
practicas
-
Informes y excel con fórmulas
He publicado nuevos practicas de 3º Laboratorio Integrado de Procesos Biotecnológicos: Informes y excel con fórmulas
apuntes
-
PRÁCTICAS LIPROC
He publicado nuevos apuntes de 3º Laboratorio Integrado de Procesos Biotecnológicos: PRÁCTICAS LIPROC
practicas
-
Informes y Excel
tuvimos buena nota
practicas
-
Prácticas
He publicado nuevos practicas de 3º Laboratorio Integrado de Procesos Biotecnológicos: Prácticas
He publicado nuevos apuntes de 3º Laboratorio Integrado de Procesos Biotecnológicos: Formulario.pdf
ejercicios
-
PROBLEMAS PARA EXAMEN
He publicado nuevos ejercicios de 3º Laboratorio Integrado de Procesos Biotecnológicos: PROBLEMAS PARA EXAMEN
He publicado nuevos apuntes de 3º Laboratorio Integrado de Procesos Biotecnológicos: problemas-resueltos-liproc.pdf
He publicado nuevos apuntes de 3º Laboratorio Integrado de Procesos Biotecnológicos: recopilacion-LIPROC.pdf
He publicado nuevos apuntes de 3º Laboratorio Integrado de Procesos Biotecnológicos: problemas-catalasa.pdf
test
-
Recopilación Test EXAMEN-CUESTIONARIOS
He publicado nuevos test de 3º Laboratorio Integrado de Procesos Biotecnológicos: Recopilación Test EXAMEN-CUESTIONARIOS
practicas
-
Informes Prácticas 2021
He publicado nuevos practicas de 3º Laboratorio Integrado de Procesos Biotecnológicos: Informes Prácticas 2021
He publicado nuevos examenes de 3º Laboratorio Integrado de Procesos Biotecnológicos: RECOPILACION-PREGUNTAS-TIPO-TEST-LIPROC.pdf
He publicado nuevos apuntes de 3º Laboratorio Integrado de Procesos Biotecnológicos: RECOPILACION-PREGUNTAS-TIPO-TEST-LIPROC.pdf
apuntes
-
Memorias
He publicado nuevos apuntes de 3º Laboratorio Integrado de Procesos Biotecnológicos: Memorias
He publicado nuevos apuntes de 3º Laboratorio Integrado de Procesos Biotecnológicos: Problemas-examenes-finales-LIPROC.pdf
apuntes
-
TEORÍA PRÁCTCAS
He publicado nuevos apuntes de 3º Laboratorio Integrado de Procesos Biotecnológicos: TEORÍA PRÁCTCAS
apuntes
-
PRÁCTICAS HECHAS + EXCEL
He publicado nuevos apuntes de 3º Laboratorio Integrado de Procesos Biotecnológicos: PRÁCTICAS HECHAS + EXCEL
He publicado nuevos examenes de 3º Laboratorio Integrado de Procesos Biotecnológicos: Problemas-Examen-LIPROC.pdf
He publicado nuevos examenes de 3º Laboratorio Integrado de Procesos Biotecnológicos: PROBLEMAS-LIPROB-JUNIO-20-21.pdf
He publicado nuevos apuntes de 3º Laboratorio Integrado de Procesos Biotecnológicos: Recopilacion-Test-LIPROC-limpio.pdf
He publicado nuevos apuntes de 3º Laboratorio Integrado de Procesos Biotecnológicos: Memoria-Tolerancia-Etanol.pdf
apuntes
-
Teoría de prácticas
He publicado nuevos apuntes de 3º Laboratorio Integrado de Procesos Biotecnológicos: Teoría de prácticas
practicas
-
Informes prácticas
He publicado nuevos practicas de 3º Laboratorio Integrado de Procesos Biotecnológicos: Informes prácticas
practicas
-
Informes
He publicado nuevos practicas de 3º Laboratorio Integrado de Procesos Biotecnológicos: Informes
He publicado nuevos apuntes de 3º Laboratorio Integrado de Procesos Biotecnológicos: apuntes-examen-liproc.pdf
He publicado nuevos apuntes de 3º Laboratorio Integrado de Procesos Biotecnológicos: EXAMEN-LIPROC-SEMANA-1.pdf
He publicado nuevos practicas de 3º Laboratorio Integrado de Procesos Biotecnológicos: Grupo-B1P.pdf
He publicado nuevos practicas de 3º Laboratorio Integrado de Procesos Biotecnológicos: Grupo-B1P.pdf
He publicado nuevos apuntes de 3º Laboratorio Integrado de Procesos Biotecnológicos: MEMORIA DEFINITIVA LIPROC.pdf
He publicado nuevos apuntes de 3º Laboratorio Integrado de Procesos Biotecnológicos: memoria liproc.pdf
He publicado nuevos practicas de 3º Laboratorio Integrado de Procesos Biotecnológicos: Memoria práctica vino.docx
He publicado nuevos practicas de 3º Laboratorio Integrado de Procesos Biotecnológicos: Memorias LIPROC.pdf
He publicado nuevos apuntes de 3º Laboratorio Integrado de Procesos Biotecnológicos: LIPROC.pdf

¡Estás al día!
Has visto todos los archivos